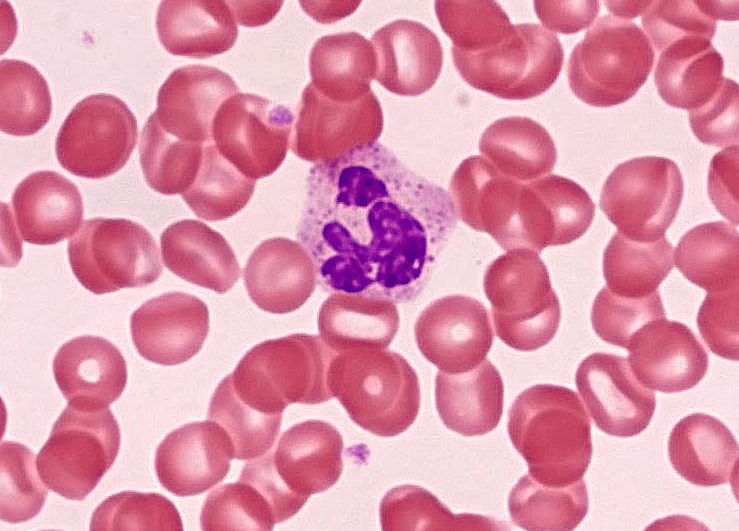
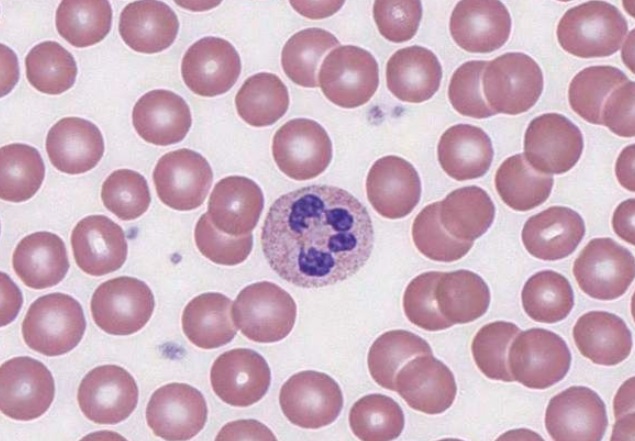
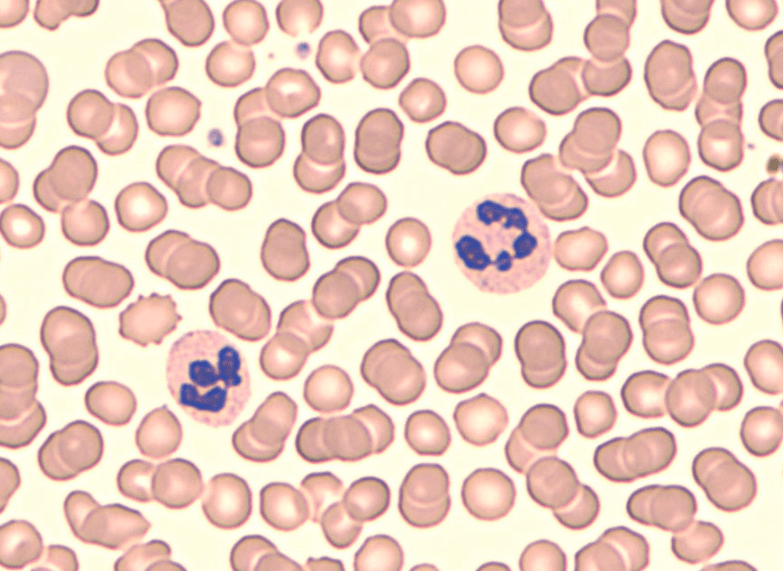
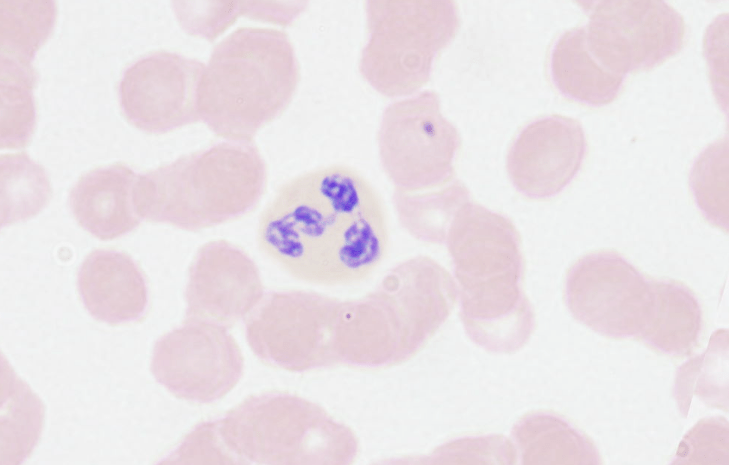
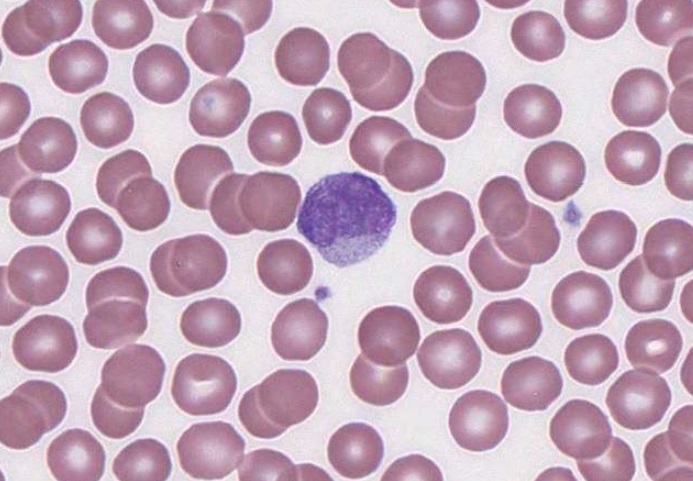
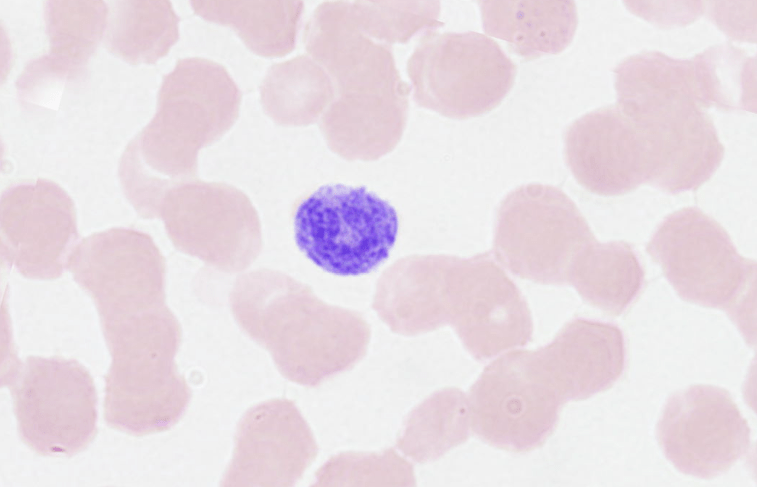
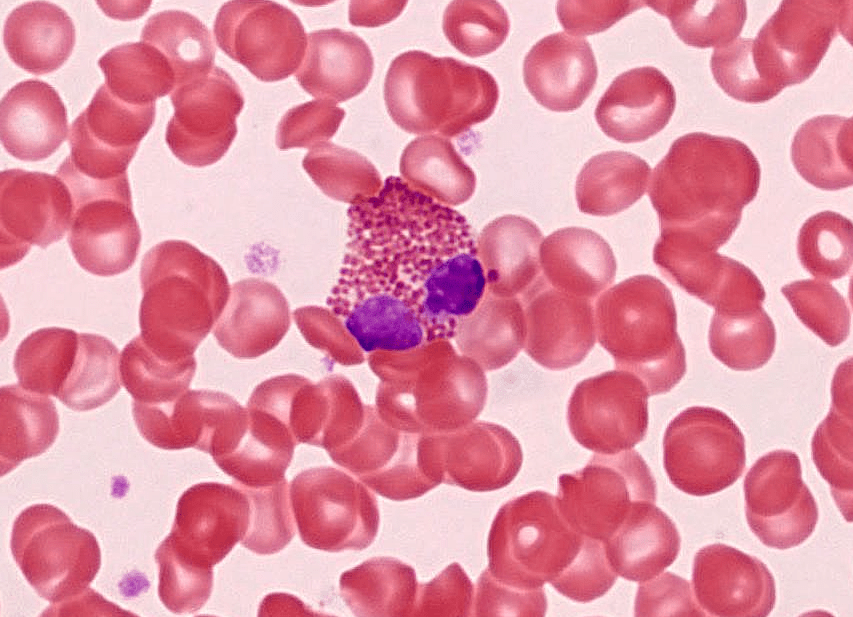
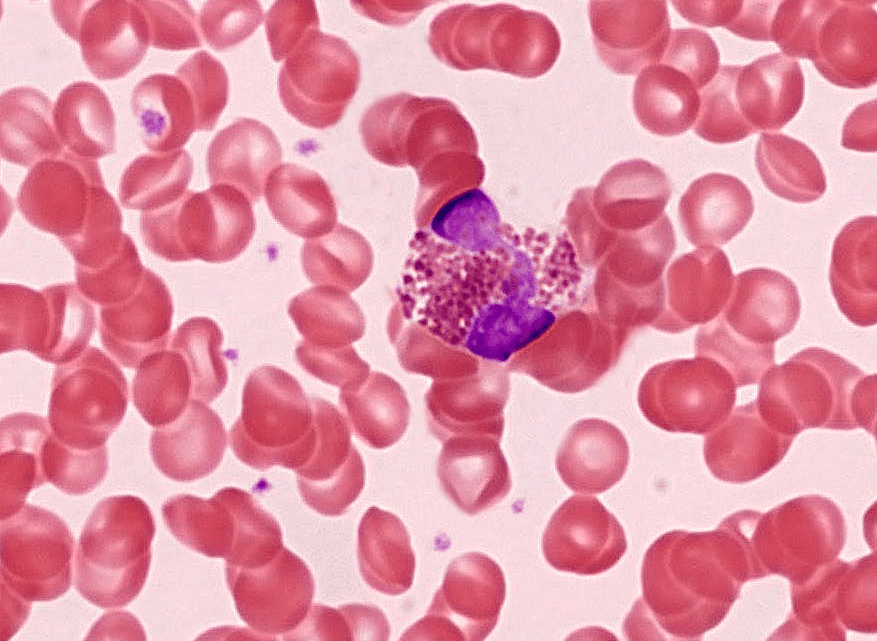
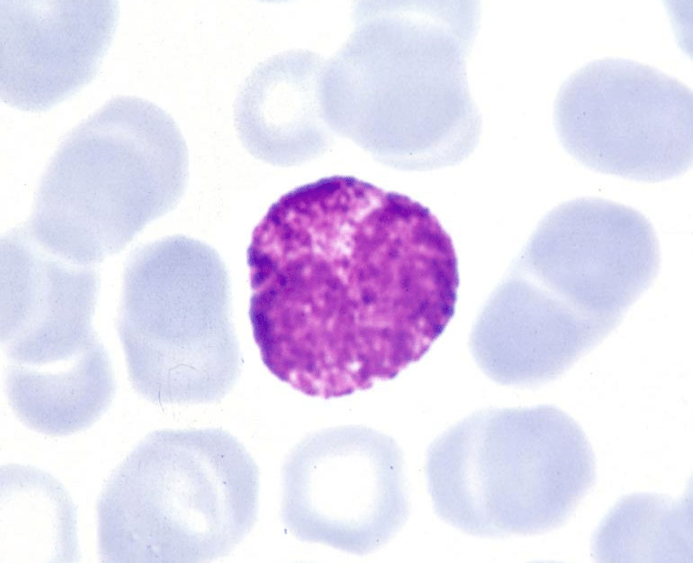
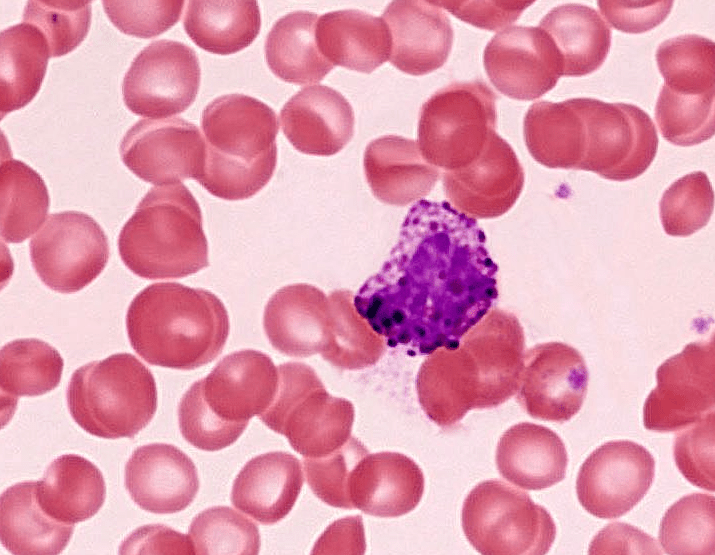
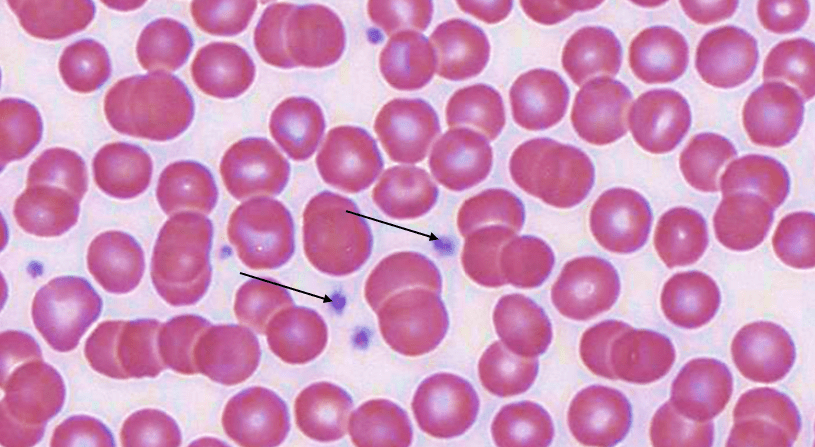
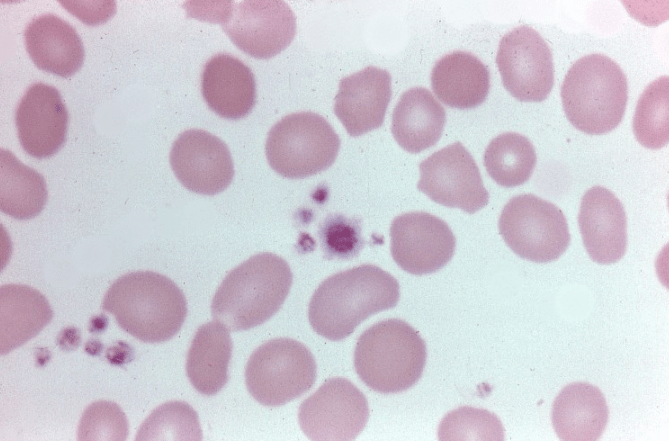

Da «click» sobre las imágenes para agrandarlas y consultar sus leyendas.
MÉDULA ÓSEA
Órgano linfoide 1°









NEUTRÓFILOS (PMN)
Porcentaje en sangre: 50-70%

LINFOCITOS
Porcentaje en sangre: 20-30%







MONOCITOS
Porcentaje en sangre: 3-8%

EOSINÓFILOS
Porcentaje en sangre: 2-4%

básica mayor (MBP).

BASÓFILOS
Porcentaje en sangre: 0-1%

¡ el núcleo no se ve !

son una fuente fundamental de la citocina IL-4.
PLAQUETAS
Cantidad normal en sangre:
150-400 × 109/L.


células grandes llamadas megacariocitos,

megacariocitos dará lugar a trombocitopenia (escasez de plaquetas)

B. Eosinófilo
C. Basófilo (núcleo en «S»)
D. Neutrófilo
E. Monocito